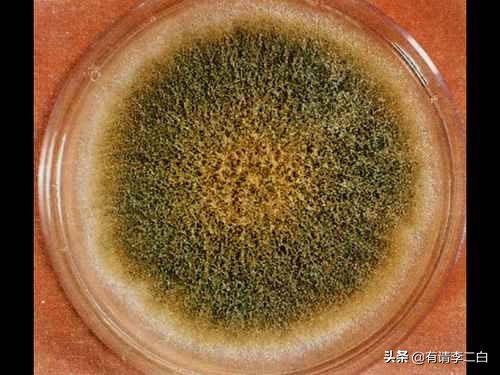
如果你不小心吃到发霉的食物,如果你不小心吃了发霉的面包

霉菌可以食用吗?
你一定在水果上见过它它吃着你的残羹剩饭 甚至可能藏在你的地窖里它就是霉菌它闻起来恶心 看着令人头皮发麻尽管你对它不甚了解但至少你知道尽量不要把它吃下去但如果你不小心误食了霉菌 会如何呢?它会对身体产生什么影响呢?会不会有某些品种的霉菌吃起来很美味?这里是《自然无常》接下来说说吃了霉菌会发生什么吧世界上有多达30万种不同的霉菌
它们能对你产生各种各样的影响有的能引起恶心和腹泻 让你难受一整天有的却能用来制作昂贵的奶酪还有一些会导致死亡那如何知道我们遇到的是哪一种霉菌呢?霉斑周围的部分还能吃吗? 我请教了一位朋友霉菌是一种微小的真菌 你能在植物上动物身上甚至墙面上见到它们霉菌的分枝像细细的线 它们被称作菌丝它们能钻进食物里 不易被发现因此人们可能忽略它们的存在如果你发现霉菌长在了食物上你可能首先会问额 我要扔掉它吗?我们总结了一些经验来帮你解决这个问题如果你在易咀嚼的食物如酸奶 果酱 桃子或西红柿里发现了霉菌你最好马上扔掉它们但如果你在较坚硬的食物如奶酪 胡萝卜或硬香肠上发现了霉菌只需把长霉的部分切掉 然后吃剩下的部分霉菌不易在质地较硬 密度较大的食物内部生长也就是说它们不能像在柔软的食物内部那样快速地生长假如你不知道这个妙招
你吃了发霉的食物会怎么样呢?最大的问题不是霉菌本身而是随着霉菌进入体内的那些有害物质首先是一种与霉菌共生且肉眼不可见的细菌如果误食这种细菌 你会胃痛 呕吐还会火急火燎地跑几趟厕所但这和误食另外一种真菌毒素所产生的危害相比可谓小巫见大巫

真菌毒素是由真菌的某些特定种类的菌株所产生的有毒物质我们能在许多食物里找到它们它们几乎能在所有的食品加工过程中存活真菌毒素种类繁多 具体来讲 约有500种其中最危险的可能就是黄曲霉毒素黄曲霉长在玉米和花生上摄入过量的黄曲霉毒素会使肝功能受损 诱发癌症 损害DNA并造成免疫系统缺陷并非所有霉菌都是有害的实际上有些人会刻意食用霉菌比如蓝纹奶酪它由两种无毒蓝色霉菌 娄阁法尔特氏青霉和灰绿青霉制成这类霉菌有抗菌作用 能够抑制病原体它们同样能分解蛋白质因此蓝纹奶酪口感光滑细腻 气味刺鼻像地球上大多数事物一样霉菌还有许多功能有待人们发现它的确可以致病但它对于
至今最有效的抗生素——青霉素的发现至关重要说不定在这个毛绒绒的蓝色物体里存在着另一种改变世界的新物质当然这是另一个假设的话题了